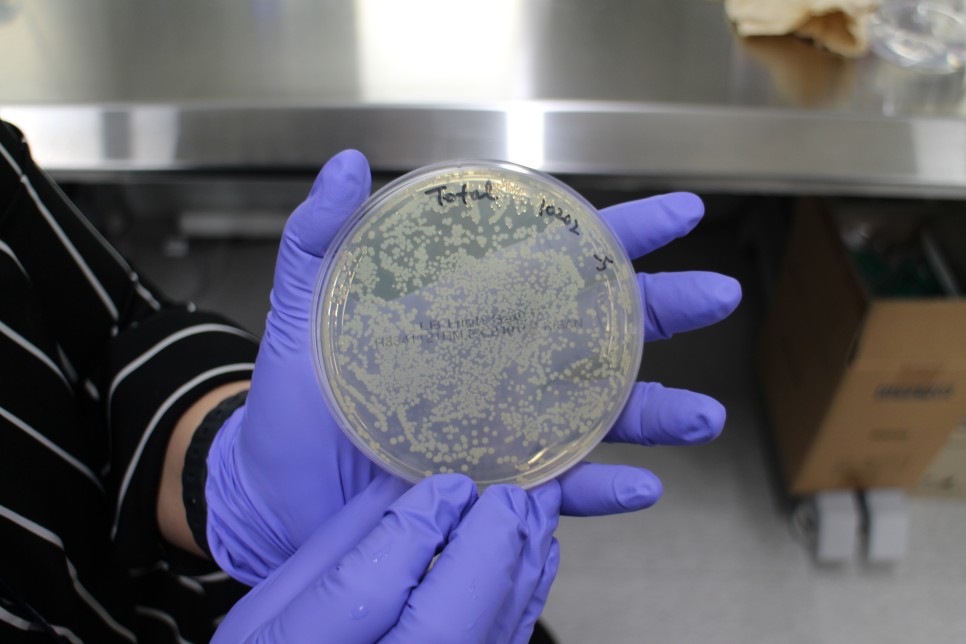

티스토리 뷰
고래와 새를 비롯, 수많은 생물을 죽음으로 몰아가는 플라스틱
분해되는데 500년이나 걸린다는 플라스틱은 막대한 양을 소비함에도 전세계 재활용률은 9%밖에 안된다.


여기 플라스틱을 분해하는 미생물이 플라스틱 처리 문제 해결사로 떠오르고 있다.
유전자 형질 전환, 머신러닝 기술, 바이오 제조, 플라즈마 처리 등 첨단 기술이 함께 하며 그 속도와 효율을 높이는데 박차를 가하고 있다.
유전자 변형으로 플라스틱 분해하는 박테리아 생성
플라스틱 분해 효소를 분비하는 박테리아는 2016년 일본 연구진이 처음 발견했다.
플라스틱이 생물체의 주 영양소인 탄소로 구성되었기 때문에 어떤 미생물에게는 좋은 먹이가 될 수 있으리라 예측했고, 정말 항구도시 사카이의 페트병 재활용 공장에서 페트를 분해해 기본 식량으로 사용하는 박테리아를 우연히 발견한 것이다. 이렇게 교토공예섬유대학 요시다 쇼스케 연구진은 ‘이데오넬라 사카이엔시스(Ideonella sakaiensis)’란 박테리아가 페트(PET) 분해능력을 가진 효소 ‘페타제(PETase)’를 분비하며 30도씨에서 6주만에 페트병을 완벽하게 분해했다고 발표했다.
현대 사회에서는 이미 화학 섬유가 의류에 폭넓게 사용되고, 재활용한 플라스틱으로 쿠션이나 인형 솜 안에 들어갈 단섬유나 가방 원단 등을 만들기도 하니 공예섬유대학에서 이런 문제 의식을 갖고 획기적인 발견을 한 것도 연관성이 있기 때문인 듯하다.
뒤이어 여러 나라에서 플라스틱 분해 효소 개발 성과를 속속 내고 있다.
유전자 형질 전환으로 PET 분해 식물성 플랑크톤 개발
2018년 한국생명공학원 세포공장연구센터 연구진은 식물성 플랑크톤인 녹색미세조류의 유전자 형질을 바꿔 플라스틱을 분해할 수 있도록 하는 방법을 개발했다. ‘이데오넬라 사카이엔시스’ 박테리아에서 분리한 PET 분해 효소(PETase)의 아미노산 서열을 이용해서 식물 플랑크톤에 적합하도록 유전자를 합성해 'Chlamydomonas reinhardtii' 라는 가장 대표적인 녹색 미세 조류에 적용하여 페트병을 분해하는 식물성 플랑크톤 'CC-124_PETase'를 개발한 것이다.
이용재·김희식 박사팀은 플라스틱 분해 식물성 플랑크톤이 음료수 페트병을 인체에 무해한 단량체들로 완전히 분해하는 과정을 관찰하는데 성공했고, 이는 세계 최초로 플라스틱을 분해하는 녹색 미세 조류를 개발한 성과다.
플라스미드로 유전자 전환 기술
네이션 크룩(노스캐롤라이나 주립대 화학 및 생체분자 공학과 조교수) 역시 유전자 전환 기술을 사용했다. 플라스틱 분해 효소를 지닌 이데오넬라 사카이엔시스 박테리아에서 DNA를 채취해 플라스미드(세포 염색체와 상관없이 세포 내에서 복제할 수 있는 유전적 서열)에 통합한 뒤 외부 미생물 세포에 몰래 삽입해 해당 세포가 플라스미드 유전 정보를 발현해 PET를 분해하는 방법을 구현한 것이다. 비브리오 나트리겐스 박테리아에 플라스미드를 도입해 실온의 바닷물 환경에서 PET를 분해할 수 있음을 입증했다.
머신러닝 기술
2022년 미국 텍사스대 연구팀은 머신러닝(ML) 기술을 통해 플라스틱을 단기간 안에 분해하는 돌연변이 효소 ‘패스트-페타제(FAST-PETase)’ 개발에 성공했다. 50℃ 아래에 페트병을 두면 분해 시간을 몇 시간에서 며칠 내로 단축시키게 된다.
플라스틱 분해 효소 대량 제조
효소로 플라스틱을 분해하면 처음 플라스틱을 만들던 재료로 나뉘어진 것과 마찬가지가 되기에 동일한 플라스틱을 만들 수 있게 된다. 플라스틱의 무한 재활용이 가능해진 것이나 마찬가지다.
프랑스 생명공학 스타트업 카비오스(Carbios)는 이를 목표로 플라스틱 직물 수명주기 분해를 촉진하는 효소 기반 공정을 개발 중이다. 카비오스는 생명공학 전문 유럽 벤처캐피털(VC)인 트러플케피털(Truffle Capital)이 2011년 설립한 회사로, 바이오 재활용을 추진하는 대표적인 기업이다. 2021년부터 프랑스 클레르몽페랑에서 효소 재활용 공장 기반이 될 기술을 시험 중이며 20㎥(세제곱미터) 규모의 생물반응기에서 효소를 사용해 20시간 안에 10만 개의 플라스틱 병을 분해할 수 있다고 한다. 해당 공장은 2025년 완공을 목표로 하며, 연간 5만 톤의 페트병 분해를 목표로 한다.


호주 환경기술 스타트업인 삼사라에코(Samsara Eco) 역시 플라스틱 분해 효소 공정을 개발하고 있다. 2022년 11월 시리즈 A에서 3,470만 달러(약 453억원)를 투자받았다. 삼사라에코는 플라스틱 폴리머를 분자로 분해할 수 있는 효소 기반 기술 개발에 성공했다.

이와같이 플라스틱 분해 효소를 공장식으로 생산하려면 분해 능력이 뛰어나야 하고 생산성, 비용 등에서 상업성이 있어야 한다. 또한 페트 외 다른 플라스틱도 분해할 수 있어야 한다.
플라즈마 처리로 속도와 효율 공략
효소가 아니라 플라즈마 처리로 분해 속도 높이는 기술도 있다.
한국핵융합에너지연구원 플라즈마기술연구소의 지상혜 박사는 미생물 및 폐플라스틱에 적용할 수 있는 플라즈마 전처리 기술 개발을 통해 미생물의 플라스틱 분해 효율을 높이는 데 성공했다.
미생물에 플라즈마 처리를 한 경우, 미생물의 개체수가 약 5배 증가했고, 산화 작용이 약 8배 이상 활발하게 일어나 플라스틱 분해 속도가 더욱 가속화되고 있음을 확인했다. 또한 연구 과정에서 폐플라스틱 분해 기능을 지닌 신규 미생물을 발굴하여 생명 자원 정보를 미국 국립생물정보센터(NCBI, National Center for Biotechnology information)에 정식 등록했다.
폐플라스틱에 플라즈마 처리를 한 후 미생물을 접종한 경우에도 보다 효율적인 분해가 일어남을 증명했다.

플라즈마 처리로 플라스틱 분해용 미생물을 활성화시키는 발명으로 특허를 출원했고 향후 환경, 농업, 신약 개발 등 응용 분야가 무궁무진하다고 한다.
플라즈마란 고체, 액체, 기체에 이은 물질의 또 다른 상태로 기체 상태에서 에너지를 가하여 만들어진다. 원자핵과 전자가 분리되어 기체 상태와 완전히 다른 특성을 지니게 되며 밝혀져 명명된지 80년밖에 되지 않았다.
플라스틱 재활용 어떻게 하나?
다이아몬드와 흑연, 식물, 우리 몸까지 지구상의 대부분의 물질은 탄소로 구성되어 있다. 그런데 플라스틱은 다른 탄소 골격 물질과 다르게 잘 분해되지 않는다. 유럽 플라스틱 산업협회인 플라
light7tree.com
'지속가능한 성장' 카테고리의 다른 글
| 뉴욕 가스렌지 금지법 통과, 과연 가스렌지는 유해한가? (0) | 2024.06.15 |
|---|---|
| 클린테크놀로지, 제주에 이런 것이 있었어? (1) | 2024.06.15 |
| 플라스틱 재활용 어떻게 하나? (0) | 2024.01.16 |
| 콩고기 찾는 심리와 제조 기술 (0) | 2023.12.20 |
| 꿀벌 실종의 비밀과 꿀벌이 대단한 뜻밖의 이유 (0) | 2023.12.15 |